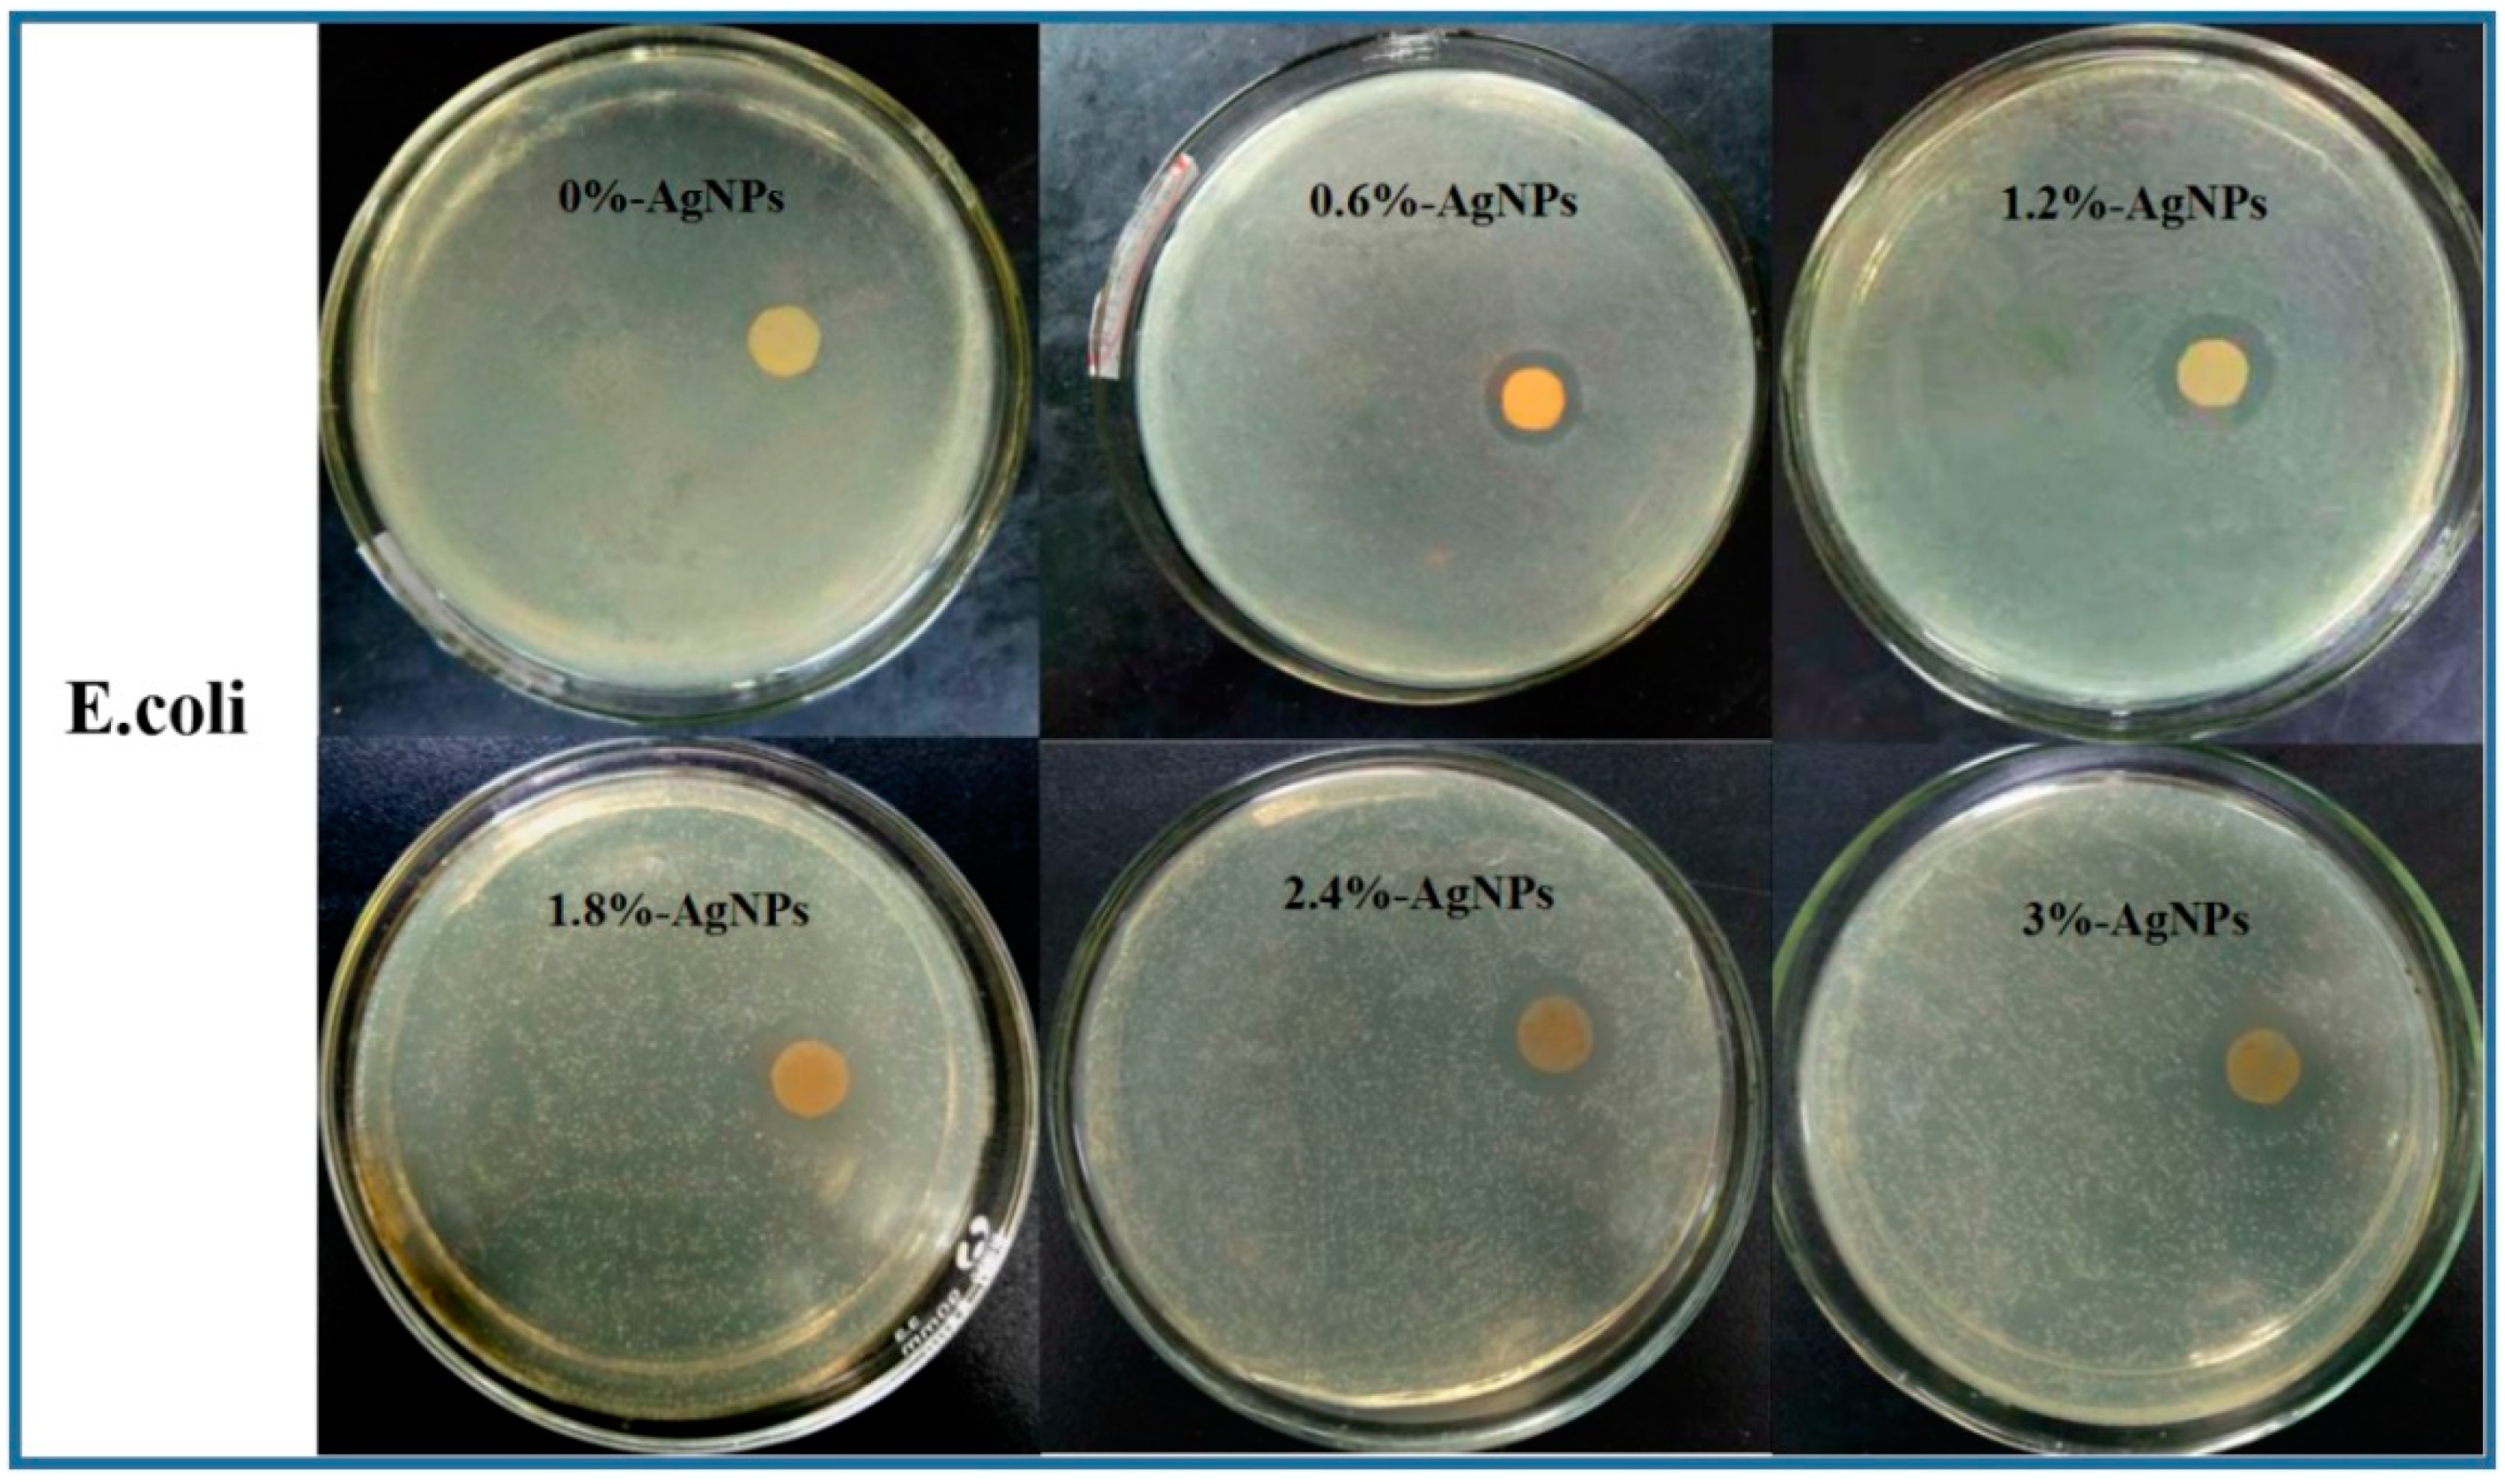
Polymers 12 00305 g009a
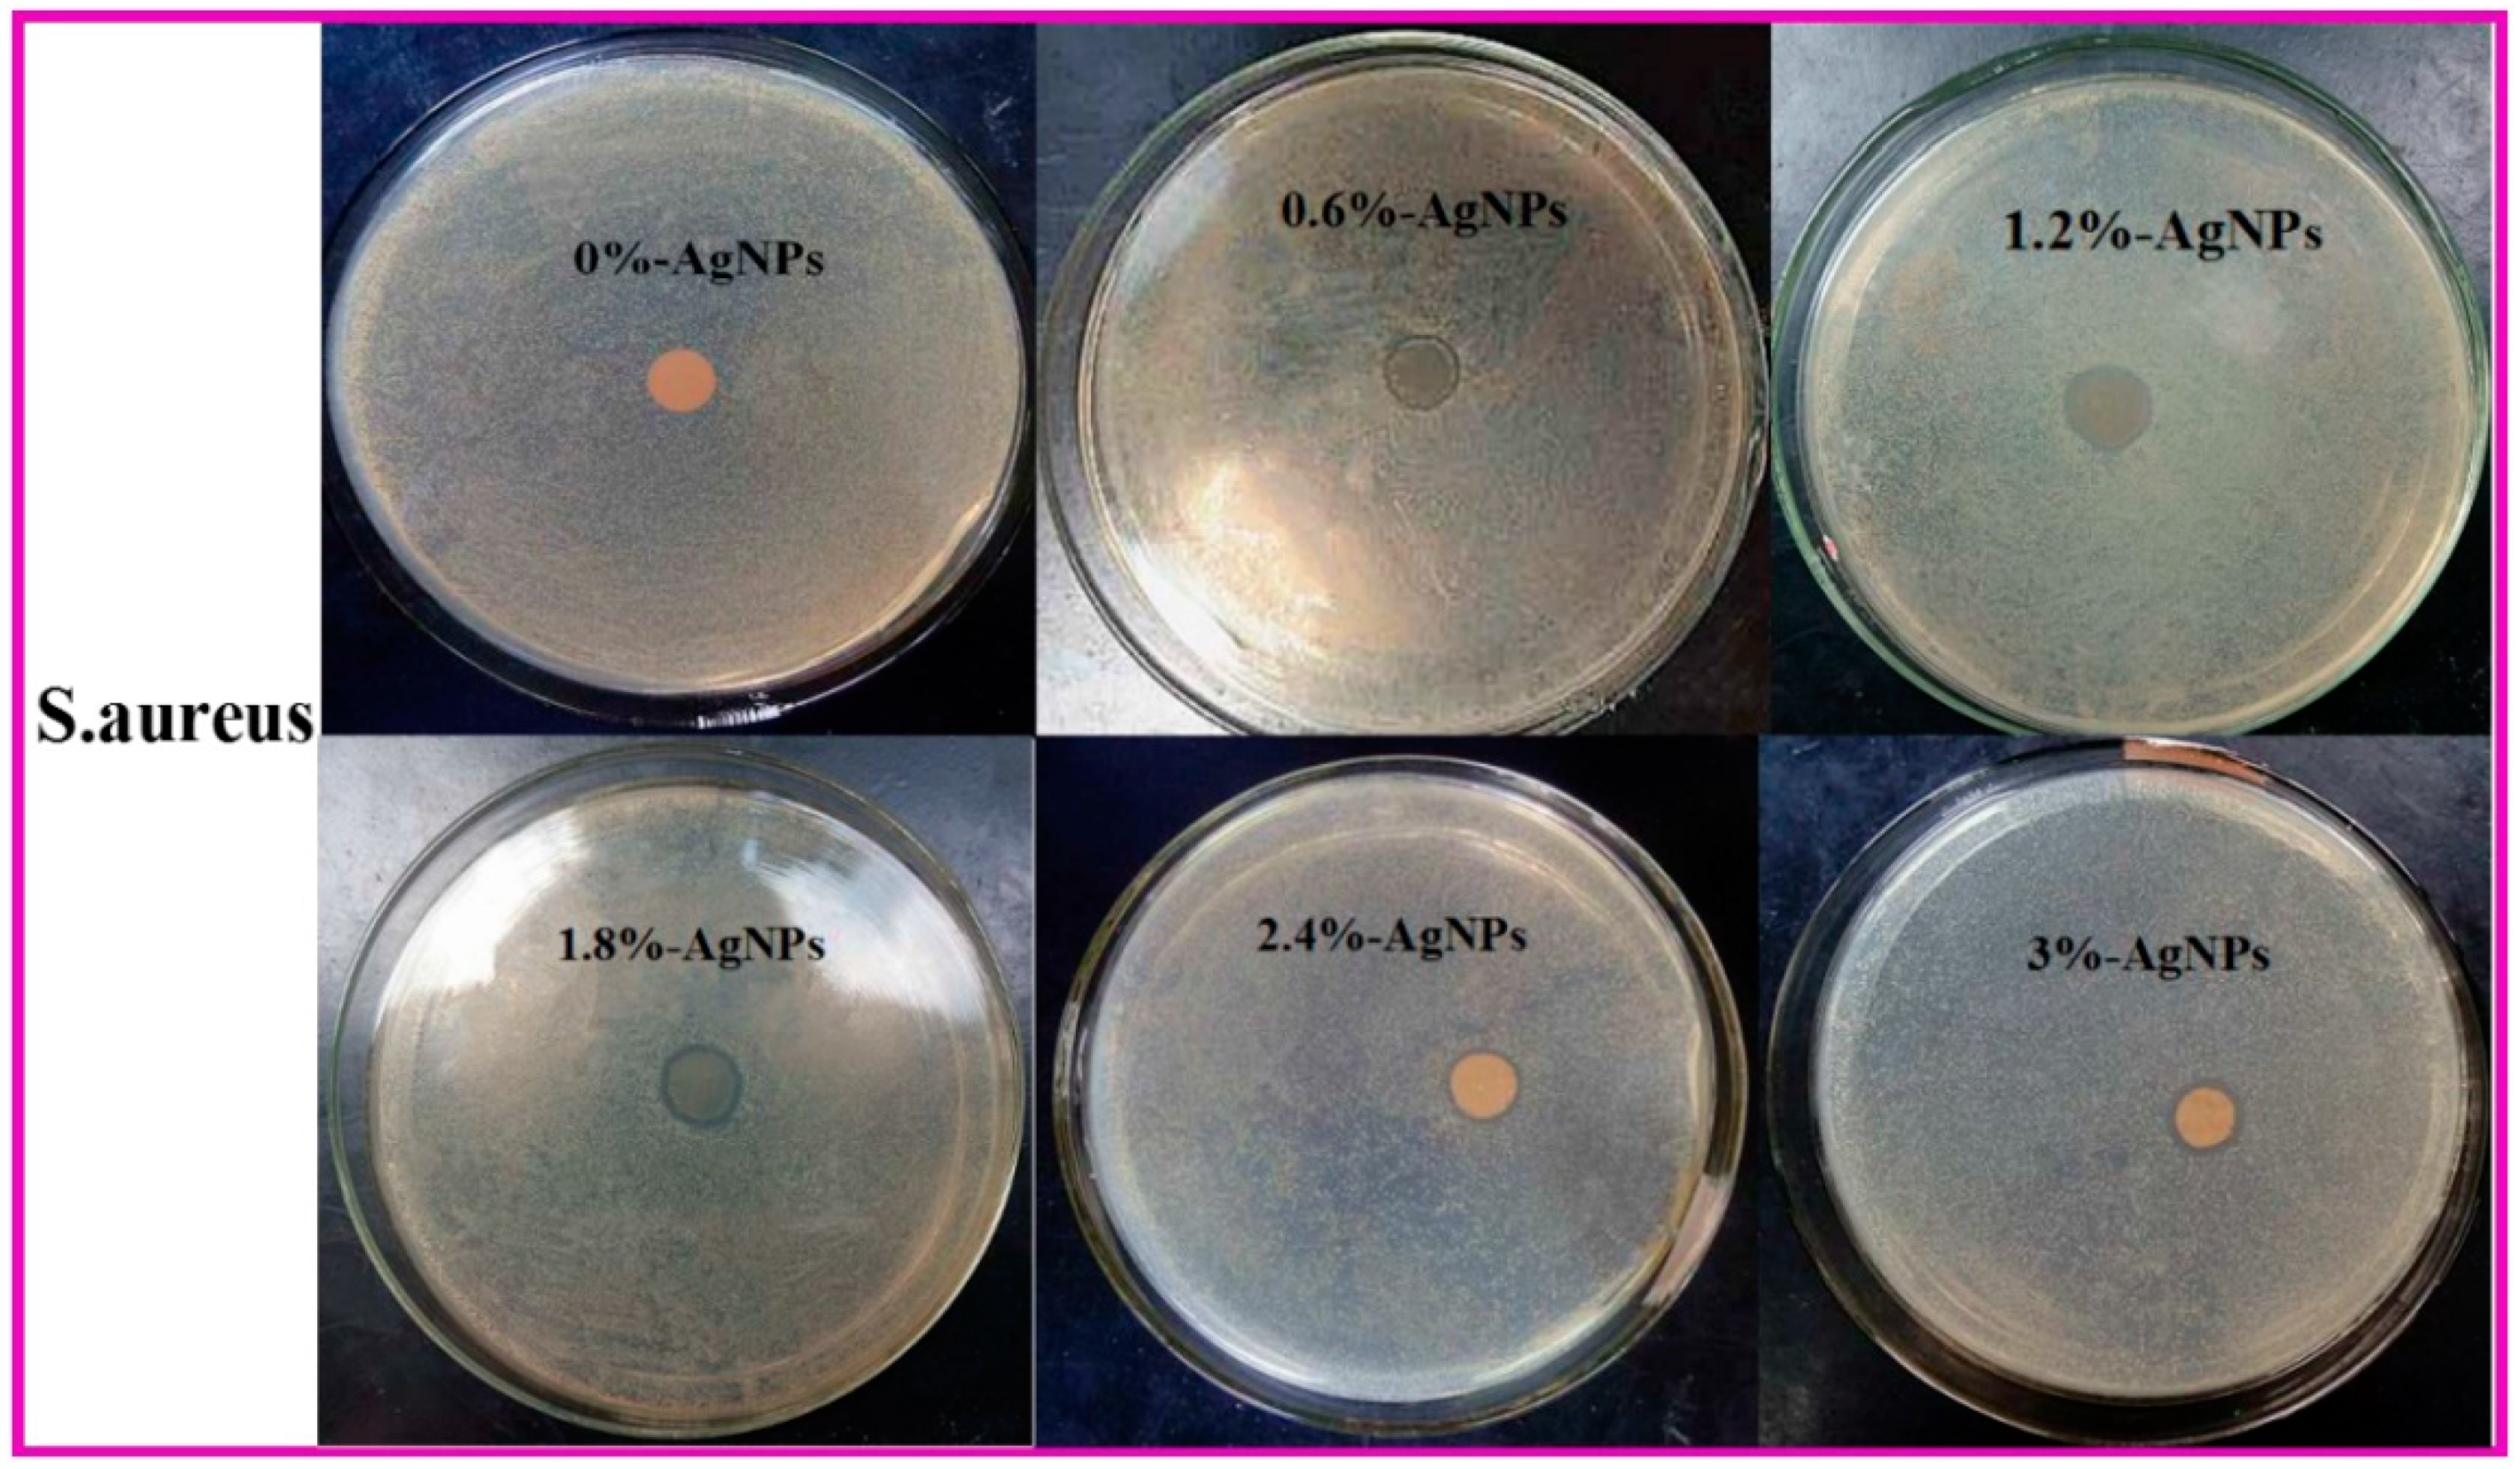
Polymers 12 00305 g009b

Electrospun Silver Nanoparticles-Embedded Feather Keratin/Poly(vinyl alcohol)/Poly(ethylene oxide) Antibacterial Composite Nanofibers
Abstract
1. Introduction
2. Materials and Methods
2.1. Materials
2.2. Synthesis of Water—Dispersible AgNPs
2.3. Preparation of Electrospinning Solutions
2.4. Electrospinning of AgNPs-Embedded FK/PVA/PEO Composite Nanofibers
2.5. Characterization
2.6. Antibacterial Assays
3. Results
3.1. Appearance and Microstructure
3.2. EDX Analysis
3.3. XRD Analysis
3.4. TG Analysis
3.5. Tensile Properties
3.6. Antibacterial Activities
4. Conclusions
Author Contributions
Funding
Conflicts of Interest
References
- Srivastava, C.M.; Purwar, R.; Gupta, A.P. Enhanced potential of biomimetic, silver nanoparticles functionalized Antheraea mylitta (tasar) silk fibroin nanofibrous mats for skin tissue engineering. Int. J. Biol. Macromol. 2019, 130, 437–453. [Google Scholar] [CrossRef] [PubMed]
- Wang, Y.F.; Li, P.F.; Xiang, P.; Lu, J.T.; Yuan, J.; Shen, J. Electrospun polyurethane/keratin/AgNP biocomposite mats for biocompatible and antibacterial wound dressings. J. Mater. Chem. B 2016, 4, 635–648. [Google Scholar] [CrossRef]
- Aluigi, A.; Tonetti, C.; Vineis, C.; Tonin, C.; Mazzuchetti, G. Adsorption of copper(II) ions by keratin/PA6 blend nanofibres. Eur. Polym. J. 2011, 47, 1756–1764. [Google Scholar] [CrossRef]
- Yin, X.C.; Li, F.Y.; He, Y.F.; Wang, Y.; Wang, R.M. Study on effective extraction of chicken feather keratins and their films for controlling drug release. Biomater. Sci. 2013, 1, 528–536. [Google Scholar] [CrossRef]
- Khadka, D.B.; Haynie, D.T. Protein- and peptide-based electrospun nanofibers in medical biomaterials. Nanomedicine 2012, 8, 1242–1262. [Google Scholar] [CrossRef]
- Zhou, H.; Shi, Z.; Wan, X.; Fang, H.; Yu, D.G.; Chen, X.; Liu, P. The relationships between process parameters and polymeric nanofibers fabricated using a modified coaxial electrospinning. Nanomaterials 2019, 9, 843. [Google Scholar] [CrossRef]
- Wang, M.L.; Hai, T.; Feng, Z.B.; Yu, D.G.; Yang, Y.Y.; Annie Bligh, S.W. The relationships between the working fluids, process characteristics and products from the modified coaxial electrospinning of zein. Polymers 2019, 11, 1287. [Google Scholar] [CrossRef]
- Yang, Y.Y.; Li, W.B.; Yu, D.G.; Wang, G.H.; Williams, G.R.; Zhang, Z. Tunable drug release from nanofibers coated with blank cellulose acetate layers fabricated using tri-axial electrospinning. Carbohydr. Polym. 2019, 203, 228–237. [Google Scholar]
- Zhao, K.; Wang, W.; Yang, Y.Y.; Wang, K.; Yu, D.G. From Taylor cone to solid nanofiber in tri-axial electrospinning: Size relationships. Results Phys. 2019, 15, 102770–102772. [Google Scholar] [CrossRef]
- Ma, H.; Shen, J.; Cao, J.; Wang, D.S.; Yue, B.B.; Mao, Z.P.; Wu, W.; Zhang, H.X. Fabrication of wool keratin/polyethylene oxide nano-membrane from wool fabric waste. J. Clean. Prod. 2017, 161, 357–361. [Google Scholar] [CrossRef]
- Park, M.; Shin, H.K.; Panthi, G.; Rabbani, M.M.; Alam, A.M.; Choi, J.; Chung, H.J.; Hong, S.T.; Kim, H.Y. Novel preparation and characterization of human hair-based nanofibers using electrospinning process. Int. J. Biol. Macromol. 2015, 76, 45–48. [Google Scholar] [CrossRef] [PubMed]
- Xu, X.Z.; Jiang, L.; Zhou, Z.P.; Wu, X.F.; Wang, Y.C. Preparation and properties of electrospun soy protein isolate/polyethylene oxide nanofiber membranes. ACS Appl. Mater. Interfaces 2012, 4, 4331–4337. [Google Scholar] [CrossRef] [PubMed]
- Cho, D.; Netravali, A.N.; Joo, Y.L. Mechanical properties and biodegradability of electrospun soy protein Isolate/PVA hybrid nanofibers. Polym. Degrad. Stab. 2012, 97, 747–754. [Google Scholar] [CrossRef]
- Colin-Orozco, J.; Zapata-Torres, M.; Rodríguez-Gattorno, G.; Pedroza-Islas, R. Properties of poly (ethylene oxide)/whey protein isolate nanofibers prepared by electrospinning. Food Biophys. 2015, 10, 134–144. [Google Scholar] [CrossRef]
- Sullivan, S.T.; Tang, C.; Kennedy, A.; Talwar, S.; Khan, S.A. Electrospinning and heat treatment of whey protein nanofibers. Food Hydrocoll. 2014, 35, 36–50. [Google Scholar] [CrossRef]
- Shalumon, K.T.; Anulekha, K.H.; Nair, S.V.; Chennazhi, K.P.; Jayakumar, R. Sodium alginate/poly(vinyl alcohol)/nano ZnO composite nanofibers for antibacterial wound dressings. Int. J. Biol. Macromol. 2011, 49, 247–254. [Google Scholar] [CrossRef]
- Castellano, M.; Alloisio, M.; Darawish, R.; Rodero, A.; Vicini, S. Electrospun composite mats of alginate with embedded silver nanoparticles: Synthesis and characterization. J. Therm. Anal. Calorim. 2019, 137, 767–778. [Google Scholar] [CrossRef]
- Abid, S.; Hussain, T.; Nazir, A.; Zahir, A.; Ramakrishna, S.; Hameed, M.; Khenoussi, N. Enhanced antibacterial activity of PEO-chitosan nanofibers with potential application in burn infection management. Int. J. Biol. Macromol. 2019, 135, 1222–1236. [Google Scholar] [CrossRef]
- Fadaie, M.; Mirzaei, E.; Asvar, Z.; Azarpira, N. Stabilization of chitosan based electrospun nanofibers through a simple and safe method. Mater. Sci. Eng. C Mater. Biol. Appl. 2019, 98, 369–380. [Google Scholar] [CrossRef]
- Kohsari, I.; Shariatinia, Z.; Pourmortazavi, S.M. Antibacterial electrospun chitosan-polyethylene oxide nanocomposite mats containing bioactive silver nanoparticles. Carbohydr. Polym. 2016, 140, 287–298. [Google Scholar] [CrossRef]
- Fan, J.; Lei, T.D.; Li, J.; Zhai, P.Y.; Wang, Y.H.; Cao, F.Y.; Liu, Y. High protein content keratin/poly (ethylene oxide) nanofibers crosslinked in oxygen atmosphere and its cell culture. Mater. Des. 2016, 104, 60–67. [Google Scholar] [CrossRef]
- Li, R.; Wang, D. Preparation of regenerated wool keratin films from wool keratin-ionic liquid solutions. J. Appl. Polym. Sci. 2013, 127, 2648–2653. [Google Scholar] [CrossRef]
- Wang, Y.Q.; Lu, Y.; Gong, J.K.; Yao, Y. Electrospun nanofiber regulates assembly of keratin and vimentin intermediate filaments of PANC-1 pancreatic carcinoma cells. Mater. Sci. Eng. C 2019, 96, 616–624. [Google Scholar] [CrossRef] [PubMed]
- Yao, C.H.; Lee, C.Y.; Huang, C.H.; Chen, Y.S.; Chen, K.Y. Novel bilayer wound dressing based on electrospun gelatin/keratin nanofibrous mats for skin wound repair. Mater. Sci. Eng. C 2017, 79, 533–540. [Google Scholar] [CrossRef] [PubMed]
- Wu, P.P.; Dai, X.Q.; Chen, K.; Li, R.; Xing, Y.J. Fabrication of regenerated wool keratin/polycaprolactone nanofiber membranes for cell culture. Int. J. Biol. Macromol. 2018, 114, 1168–1173. [Google Scholar] [CrossRef]
- Jin, E.; Reddy, N.; Zhu, Z.F.; Yang, Y.Q. graft polymerization of native chicken feathers for thermoplastic applications. J. Agric. Food Chem. 2011, 59, 1729–1738. [Google Scholar] [CrossRef]
- Singh, P.; Garg, A.; Pandit, S.; Mokkapati, V.R.S.S.; Mijakovic, I. antimicrobial effects of biogenic nanoparticles. Nanomaterials 2018, 8, 1009. [Google Scholar] [CrossRef]
- Aktürk, A.; Taygun, M.E.; Güler, F.K.; Goller, G.; Küçükbayrak, S. Fabrication of antibacterial polyvinylalcohol nanocomposite mats with soluble starch coated silver nanoparticles. Colloids Surf. A Physicochem. Eng. Asp. 2019, 562, 255–262. [Google Scholar] [CrossRef]
- Thanh, N.T.; Hieu, M.H.; Phuong, N.T.M.; Thuan, T.D.B.; Thu, H.N.T.; Do Minh, T. Optimization and characterization of electrospun polycaprolactone coated with gelatin-silver nanoparticles for wound healing application. Mater. Sci. Eng. C 2018, 91, 318–329. [Google Scholar] [CrossRef]
- Pierini, F.; Lanzi, M.; Nakielski, P.; Kowalewski, T.A. Electrospun polyaniline-based composite nanofibers: Tuning the electrical conductivity by tailoring the structure of thiol-protected metal nanoparticles. J. Nanomater. 2017, 2017, 6142140. [Google Scholar] [CrossRef]
- Hadipour-Goudarzi, E.; Montazer, M.; Latifi, M. Electrospinning of chitosan/sericin/PVA nanofibers incorporated with in situ synthesis of nano silver. Carbohydr. Polym. 2014, 113, 231–239. [Google Scholar] [CrossRef] [PubMed]
- Ding, J.; Chen, M.; Chen, W.J.; He, M.; Zhou, X.Y.; Yin, G.Q. Vapor-assisted crosslinking of a FK/PVA/PEO nanofiber membrane. Polymers 2018, 10, 747. [Google Scholar] [CrossRef] [PubMed]
- He, M.; Zhang, B.N.; Dou, Y.; Yin, G.Q.; Cui, Y.D.; Chen, X.J. Fabrication and characterization of electrospun feather keratin/poly (vinyl alcohol) composite nanofibers. RSC Adv. 2017, 7, 9854–9861. [Google Scholar] [CrossRef]
- Zhang, Z.; Wu, Y.; Wang, Z.; Zou, X.; Zhao, Y.; Sun, L. Fabrication of silver nanoparticles embedded into polyvinyl alcohol (Ag/PVA) composite nanofibrous films through electrospinning for antibacterial and surface-enhanced Raman scattering (SERS) activities. Mater. Sci. Eng. C 2016, 69, 462–469. [Google Scholar] [CrossRef]
- Yang, Y.; Zhu, T.; Liu, Z.P.; Luo, M.; Yu, D.G.; Annie Bligh, S.W. The key role of straight fluid jet in predicting the drug dissolution from electrospun nanofibers. Int. J. Pharm. 2019, 569, 118634. [Google Scholar] [CrossRef]
- Choudhary, S. Dielectric dispersion and relaxations in (PVA-PEO)-ZnO polymer nanocomposites. Phys. B Condens. Matter 2017, 522, 48–56. [Google Scholar] [CrossRef]
- Fan, J.; Yu, W.D. High yield preparation of keratin powder from wool fiber. Fibers Polym. 2012, 13, 1044–1049. [Google Scholar] [CrossRef]
- Li, S.; Yang, X.H. Fabrication and characterization of electrospun wool keratin/poly (vinyl alcohol) blend nanofibers. Adv. Mater. Sci. Eng. 2014, 2014, 163678. [Google Scholar] [CrossRef]
- Lee, D.; Lee, S.J.; Moon, J.H.; Kim, J.H.; Heo, D.N.; Bang, J.B.; Lim, H.N.; Kwon, I.K. Preparation of antibacterial chitosan membranes containing silver nanoparticles for dental barrier membrane applications. J. Ind. Eng. Chem. 2018, 66, 196–202. [Google Scholar] [CrossRef]
- An, J.; Luo, Q.Z.; Yuan, X.Y.; Wang, D.S.; Li, X.Y. Preparation and characterization of silver-chitosan nanocomposite particles with antimicrobial activity. J. Appl. Polym. Sci. 2011, 120, 3180–3189. [Google Scholar] [CrossRef]
- Mokhena, T.C.; Luyt, A.S. Electrospun alginate nanofibres impregnated with silver nanoparticles: Preparation, morphology and antibacterial properties. Carbohydr. Polym. 2017, 165, 304–312. [Google Scholar] [CrossRef] [PubMed]
- Wang, X.L.; Cheng, F.; Gao, J. Antibacterial wound dressing from chitosan/polyethylene oxide nanofibers mats embedded with silver nanoparticles. J. Biomater. Appl. 2014, 29, 1086–1095. [Google Scholar] [CrossRef] [PubMed]
- Maharjan, B.; Joshi, M.K.; Tiwari, A.P.; Park, C.H.; Kim, C.S. In-situ synthesis of AgNPs in the natural/synthetic hybrid nanofibrous scaffolds: Fabrication, characterization and antimicrobial activities. J. Mech. Behav. Biomed. Mater. 2017, 65, 66–76. [Google Scholar] [CrossRef] [PubMed]
- Sondi, I.; Salopek-Sondi, B. Silver nanoparticles as antimicrobial agent: A case study on E. coli as a model for Gram-negative bacteria. J. Colloid Interface Sci. 2004, 275, 177–182. [Google Scholar] [CrossRef]
- Kanmani, P.; Rhim, J.W. Physicochemical properties of gelatin/silver nanoparticle antimicrobial composite films. Food Chem. 2014, 148, 162–169. [Google Scholar] [CrossRef]
- Wani, I.A.; Khatoon, S.; Ganguly, A.; Ahmed, J.; Ahmad, T. Structural characterization and antimicrobial properties of silver nanoparticles prepared by inverse microemulsion method. Colloids Surf. B Biointerfaces 2013, 101, 243–250. [Google Scholar] [CrossRef]
- Kharaghani, D.; Jo, Y.K.; Khan, M.Q.; Jeong, Y.; Cha, H.J.; Kim, I.S. Electrospun antibacterial polyacrylonitrile nanofiber membranes functionalized with silver nanoparticles by a facile wetting method. Eur. Polym. J. 2018, 108, 69–75. [Google Scholar] [CrossRef]
- Selvaraj, S.; Thangam, R.; Fathima, N.N. Electrospinning of casein nanofibers with silver nanoparticles for potential biomedical applications. Int. J. Biol. Macromol. 2018, 120, 1674–1681. [Google Scholar] [CrossRef]
- Liu, Y.N.; Liu, Y.; Liao, N.N.; Cui, F.H.; Park, M.; Kim, H.Y. Fabrication and durable antibacterial properties of electrospun chitosan nanofibers with silver nanoparticles. Int. J. Biol. Macromol. 2015, 79, 638–643. [Google Scholar] [CrossRef]
- Fouda, M.M.G.; El-Aassar, M.R.; Al-Deyab, S.S. Antimicrobial activity of carboxymethyl chitosan/polyethylene oxide nanofibers embedded silver nanoparticles. Carbohydr. Polym. 2013, 92, 1012–1017. [Google Scholar] [CrossRef]
- Kalwar, K.; Sun, W.X.; Li, D.L.; Zhang, X.J.; Shan, D. Coaxial electrospinning of polycaprolactone@chitosan: Characterization and silver nanoparticles incorporation for antibacterial activity. React. Funct. Polym. 2016, 107, 87–92. [Google Scholar] [CrossRef]

| Samples | Average Diameters (nm) |
|---|---|
| 0%-AgNPs | 249.76 ± 38.02 |
| 0.6%-AgNPs | 209.41 ± 21.93 |
| 1.2%-AgNPs | 187.76 ± 27.90 |
| 1.8%-AgNPs | 179.55 ± 27.95 |
| 2.4%-AgNPs | 167.78 ± 23.38 |
| 3.0%-AgNPs | 160.30 ± 25.53 |
| Sample (%) | T10 (°C) | Tmax1 (°C) | Tmax2 (°C) |
|---|---|---|---|
| 0%-AgNPs | 240 | 255 | 406 |
| 0.6%-AgNPs | 245 | 262 | 408 |
| 1.2%-AgNPs | 250 | 264 | 409 |
| 1.8%-AgNPs | 253 | 267 | 410 |
| 2.4%-AgNPs | 254 | 272 | 411 |
| 3%-AgNPs | 256 | 273 | 413 |
| Samples | TS (MPa) | EAB (%) |
|---|---|---|
| 0%-AgNPs | 2.62 ± 0.51 | 42.75 ± 0.25 |
| 0.6%-AgNPs | 4.30 ± 0.64 | 31.25 ± 5.30 |
| 1.2%-AgNPs | 5.52 ± 0.71 | 51.50 ± 9.19 |
| 1.8%-AgNPs | 4.83 ± 1.23 | 30.50 ± 5.57 |
| 2.4%-AgNPs | 2.60 ± 0.51 | 20.93 ± 10.42 |
| 3.0%-AgNPs | 2.38 ± 0.57 | 12.5 ± 3.27 |
| Samples | Diameter of Antibacterial Inhibition (mm) | |
|---|---|---|
| E. coli | S. aureus | |
| 0%-AgNPs | 0 | 0 |
| 0.6%-AgNPs | 5.02 | 2.12 |
| 1.2%-AgNPs | 8.24 | 2.08 |
| 1.8%-AgNPs | 8.40 | 1.70 |
| 2.4%-AgNPs | 8.17 | 1.56 |
| 3.0%-AgNPs | 8.60 | 2.96 |
© 2020 by the authors. Licensee MDPI, Basel, Switzerland. This article is an open access article distributed under the terms and conditions of the Creative Commons Attribution (CC BY) license (http://creativecommons.org/licenses/by/4.0/).
Share and Cite
He, M.; Chen, M.; Dou, Y.; Ding, J.; Yue, H.; Yin, G.; Chen, X.; Cui, Y. Electrospun Silver Nanoparticles-Embedded Feather Keratin/Poly(vinyl alcohol)/Poly(ethylene oxide) Antibacterial Composite Nanofibers. Polymers 2020, 12, 305. https://doi.org/10.3390/polym12020305
He M, Chen M, Dou Y, Ding J, Yue H, Yin G, Chen X, Cui Y. Electrospun Silver Nanoparticles-Embedded Feather Keratin/Poly(vinyl alcohol)/Poly(ethylene oxide) Antibacterial Composite Nanofibers. Polymers. 2020; 12(2):305. https://doi.org/10.3390/polym12020305
Chicago/Turabian StyleHe, Ming, Man Chen, Yao Dou, Jiao Ding, Hangbo Yue, Guoqiang Yin, Xunjun Chen, and Yingde Cui. 2020. "Electrospun Silver Nanoparticles-Embedded Feather Keratin/Poly(vinyl alcohol)/Poly(ethylene oxide) Antibacterial Composite Nanofibers" Polymers 12, no. 2: 305. https://doi.org/10.3390/polym12020305
APA StyleHe, M., Chen, M., Dou, Y., Ding, J., Yue, H., Yin, G., Chen, X., & Cui, Y. (2020). Electrospun Silver Nanoparticles-Embedded Feather Keratin/Poly(vinyl alcohol)/Poly(ethylene oxide) Antibacterial Composite Nanofibers. Polymers, 12(2), 305. https://doi.org/10.3390/polym12020305






